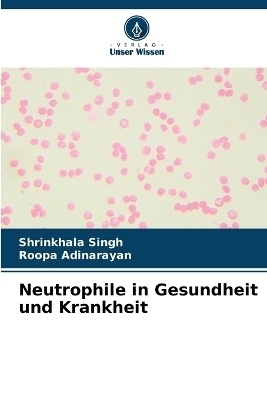
Neutrophile in Gesundheit und Krankheit

Buch | Softcover
2023
|
Verlag Unser Wissen
ISBN: 9786205629406
CHF 57,25 (inkl. MwSt)
- Keine Verlagsinformationen verfü
gbar